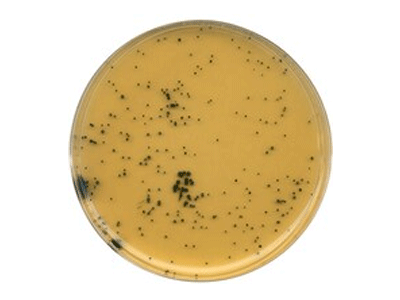
Tryptose-Sulfite-Cycloserine Tryptose-Sulfite-Cycloserine

Mô tả
Hóa chất TSC (Tryptose Sulfite Cycloserine) agar (base) Merck
Mã code: 1119720500
Thương hiệu: Merck – Đức
Mô tả nhanh
Tên gọi khác: TSC-agar, Tryptose sulfite cycloserine agar
Ứng dụng:Tryptone sulfit Cycloserine Agar do Harmon phát triển được dùng để phân lập chọn lọc và đếm Clostridium perfringens trong các mẫu nước và thực phẩm.
Môi trường này thích hợp cho việc đếm các vi khuẩn yếm khí tiêu thụ sulfite từ thực phẩm có nguồn gốc động vật.
VNĐ 4.273.000 – 5.260.000
Quy cách: Chai nhựa 500g
Màu sắc: Nâu
pH(25°C): 7.4 – 7.8
Thành phần chính (g/l): Tryptose 15.0; Peptone from soymeal 5.0; Yeast extract 5.0; Sodium dusilfit 1.0;
Ammonium iron(III) citrate 1.0; Agar-agar 12.0.
Độ hòa tan: 42 g/l
Điều kiện bảo quản: Bảo quản ở nhiệt độ +15°C đến +25°C.

Đánh giá
Chưa có đánh giá nào.